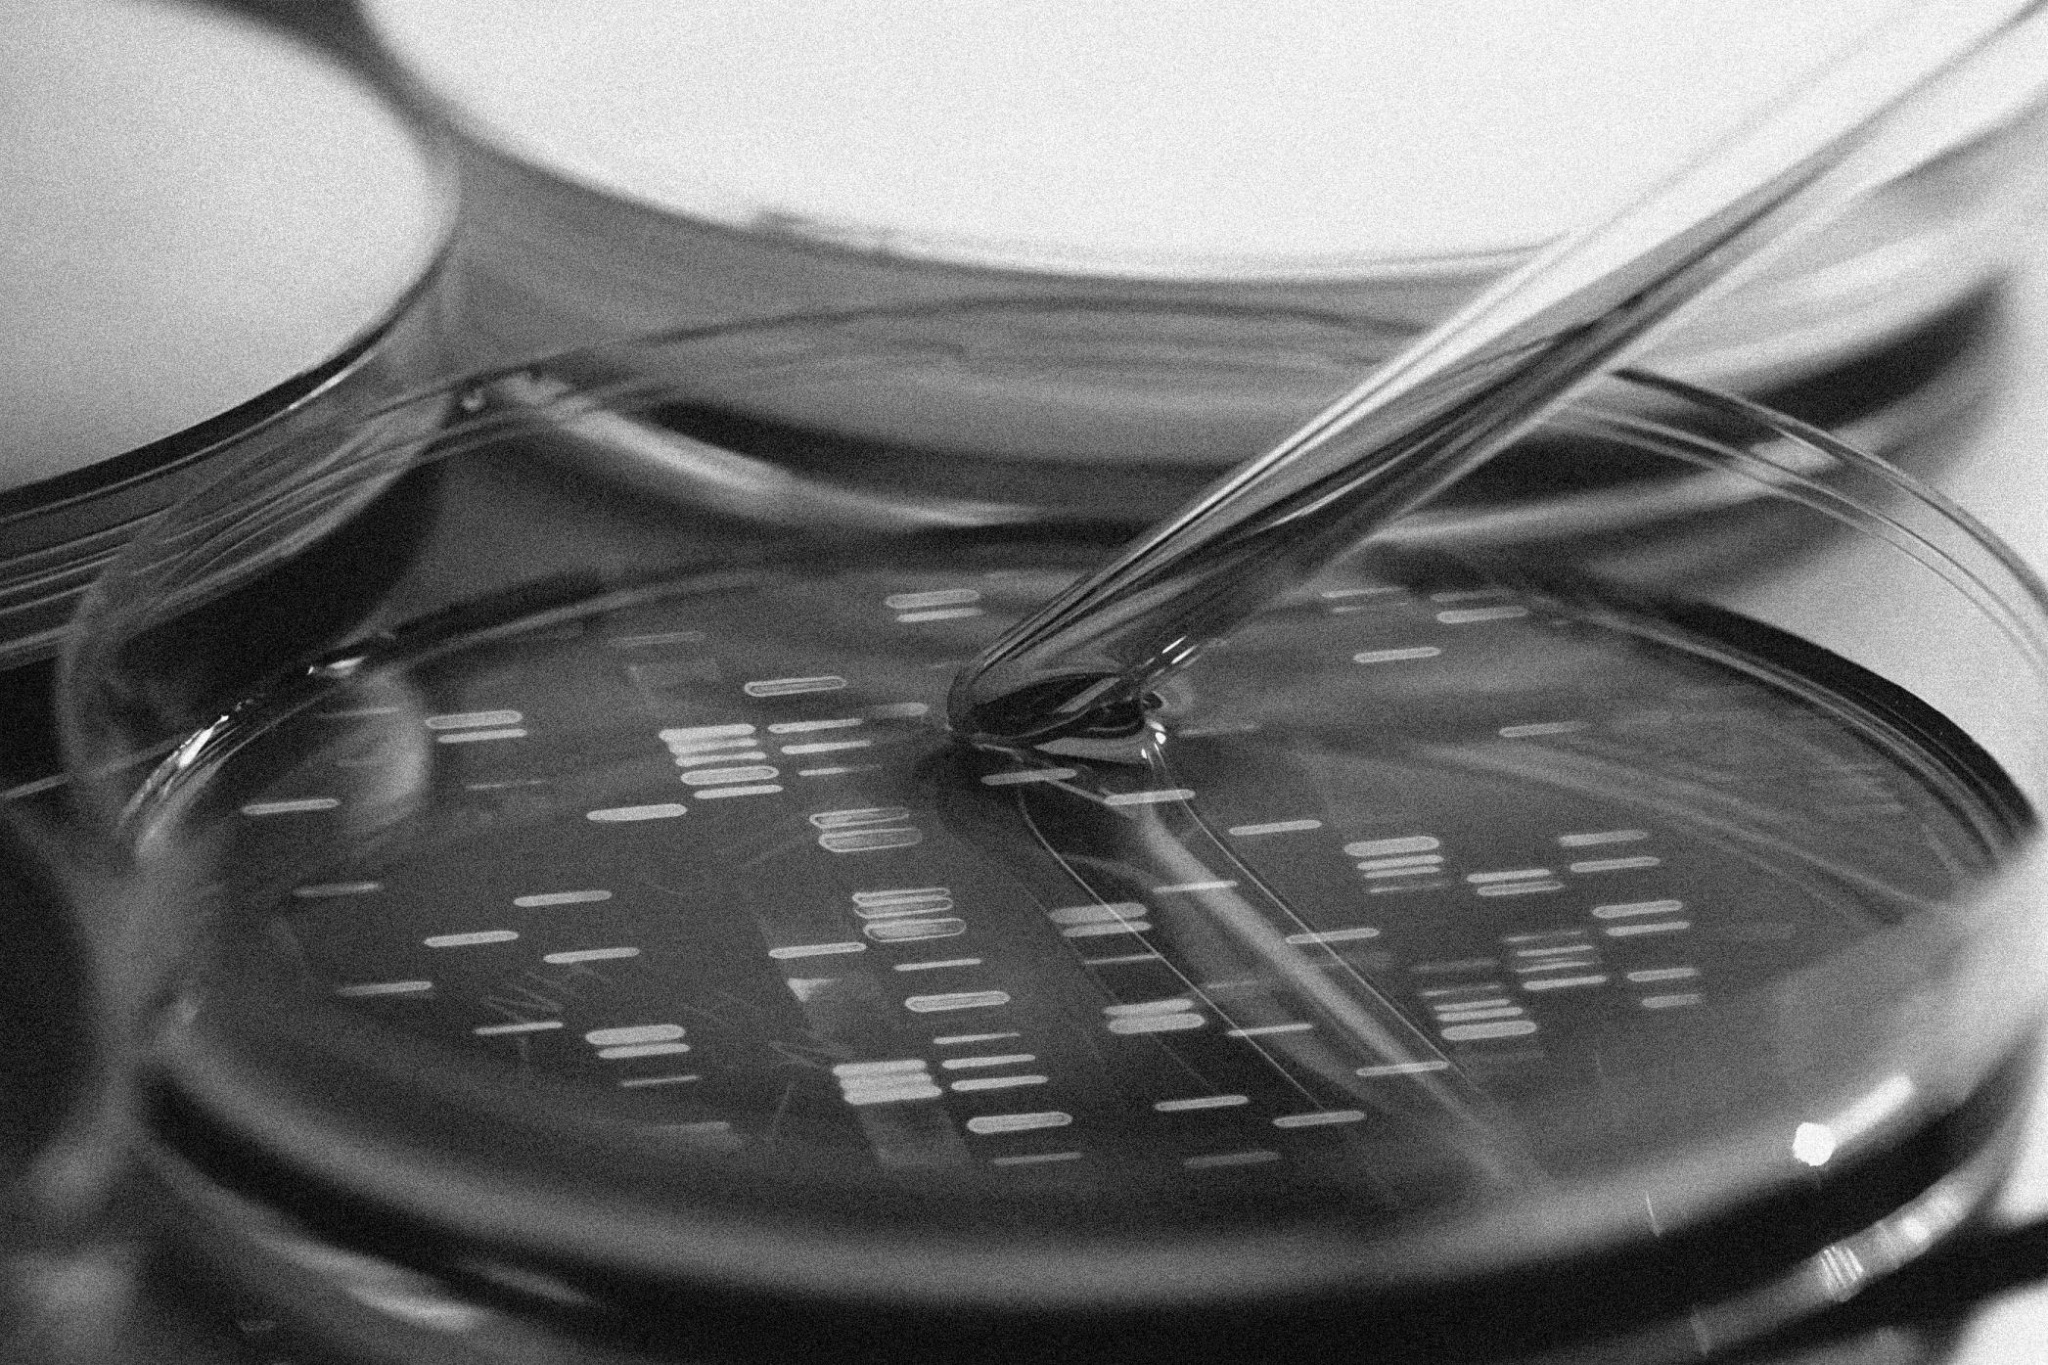
756776810817725.jpg

Почему мы стареем и способна ли наука взломать этот процесс
Биолог, научный журналист Ирина Якутенко — о механизмах старения тела и о том, может ли предельный средний возраст человека превышать 120 лет

Люди с незапамятных времен пытались найти способ продлить жизнь и отсрочить старость. И надо сказать, им это в значительной мере удалось: если в XVIII веке 50-летний человек считался стариком и до этого возраста доживало меньше 20%, то сейчас во многих странах люди только в 65‒67 выходят на пенсию, а многие и после этого продолжают активно работать. Ожидаемая продолжительность жизни, как минимум в развитых странах, растет с каждым годом, и для рекордсменов — японских женщин и женщин из Гонконга — составляет 88 лет. Скорее всего, рано или поздно этот тренд остановится, но многие ученые уверены, что пока мы не достигли предела. И хотя большинство известных долгожителей умирали в возрасте около 110 лет, с середины XIX века они тоже живут все дольше и дольше. Наиболее известные попытки вычислить потолок теоретически возможной продолжительности жизни на основании текущих закономерностей оценивают его примерно в 120 лет — но пока мы знаем только одного человека, который дожил до этого возраста: француженка Жанна Кальман умерла через пять месяцев после своего 122-го дня рождения.
Помимо собственно продолжительности жизни, людей беспокоит и то, как долго они смогут сохранять большинство или хотя бы некоторые возможности и показатели здоровья молодых. Продолжительность здорового долголетия также растет, однако чем старше становится человек, тем заметнее у него проявляются те или иные признаки старения. Более того, иногда отдельные симптомы старости детектируют у совсем молодых людей, и это существенно повышает их риски умереть намного раньше «положенного». Сегодня ученые выявили уже много таких признаков, к тому же у специалистов есть примерная картина, что и как выходит из строя с возрастом. Ниже мы рассмотрим основные этапы старения на разных уровнях, а затем обсудим гипотезы, объясняющие, почему с нами происходят все эти неприятные события и можно ли их отменить.
Как мы стареем
На уровне организма старение проявляется целым рядом болезней, вероятность появления которых тем выше, чем мы старше. Высокое давление, сердечно-сосудистые нарушения, диабет второго типа, остеопороз, остеоартрит, болезнь Альцгеймера, болезнь Паркинсона, определенные виды рака — редко можно найти человека старше 60 лет, у которого не было бы одного или нескольких подобных возрастных расстройств. Такая единообразная картина указывает, что у всех этих нарушений имеются некие общие причины. И действительно, сегодня ученые обнаружили и описали многие из них.
Любые системные расстройства начинаются со сбоев в работе отдельных клеток, в которых, в свою очередь, начинают барахлить те или иные компоненты. И самые уязвимые в этом отношении составляющие клеток — это молекулы ДНК и белков. ДНК — самая долгоживущая клеточная молекула, и с возрастом она портится сразу множеством способов. Во-первых, в ДНК накапливаются мутации, которые клеточные системы ремонта не успели или не смогли качественно исправить. Если таких изменений оказывается слишком много, клетка не может нормально выполнять свою работу, и, по мере того как количество подобных бесполезных клеток увеличивается, различные ткани и органы постепенно выходят из строя. Исследования долгожителей показали, что в их ДНК накапливается меньше мутаций, чем в среднем, более того, у долгожителей оказалось меньше мутаций, чем у молодых и (пока еще) здоровых людей, что позволяет предположить, что у таких людей механизмы починки ДНК работают заметно эффективнее.
В совсем испортившихся клетках фрагменты ДНК вываливаются из ядра в цитоплазму (внутриклеточное пространство), и это запускает цикл воспалительных реакций, привлекающих иммунные клетки, которые должны уничтожить такой полутруп. Но воспалительные реакции далеки от оптимальных и часто повреждают окружающие здоровые клетки, поэтому хроническое воспаление — еще одно типичное возрастное изменение — заметно ускоряет «амортизацию» организма.
Помимо накопления мутаций, с каждым циклом деления молекулы ДНК становятся немного короче. Это происходит из-за того, что копирующий ДНК фермент не может синтезировать концевые участки хромосом — особых структур из ДНК и белков, в форме которых в наших клетках хранится наследственная информация. В результате хромосомы постепенно укорачиваются, но довольно долго это не приносит клеткам вреда, так как на концах хромосом находятся специальные участки ДНК, которые не содержат генов. Эти участки называют теломерами, и они защищают хромосомы от повреждений точно так же, как набойки защищают каблуки обуви.